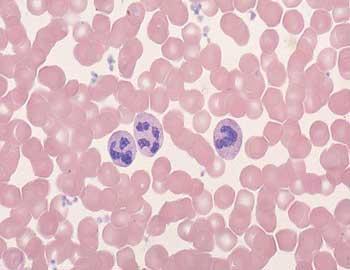

Quais são os valores normais de neutrófilos


Os neutrófilos são o tipo mais comum de glóbulos brancos, compreendem entre 50% e 70% dos leucócitos do sangue. Em laboratório distinguem-se do resto por mudarem de cor facilmente com colorantes neutros. A função que desempenham no sistema imune é a destruição de bactérias, partículas sólidas e restos celulares. Em umComo.com.br ajudamos você a conhecer quais são os valores de neutrófilos no sangue.
Valores normais de neutrófilos
Quando uma infecção chega ao organismo, os neutrófilos são as primeiras células imunes que detectam o ataque. Eles têm uma vida curta mas são muito rápidos frente aos agentes patogênicos e são o componente principal do pus e os responsáveis pela cor esbranquiçada.
O número de neutrófilos encontra-se no compartimento do hemograma na analítica sanguínea. Seus valores normais ficam entre: 2000 e 7500/ml.
Valores normais de neutrófilos
Um número alto de neutrófilos no sangue é sinal de que algo no corpo desencadeou a resposta imune. Quando os valores são altos ocorre a neutrofilia, que normalmente é o resultado de uma infecção ou estresse físico. Consulte seu médico se deve tomar alguma medida ou tratamento.
Valores baixos de neutrófilos
Quando a contagem de neutrófilos no sangue é inferior a 2000/ml estamos perante a neutropenia, sua origem pode ser congênita ou adquirida (leucemia, quimioterapia e inclusive alguns tipos de anemias). Quando a neutropenia é grave, como os neutrófilos são uma parte importante do sistema imune, as bactérias presentes na boca e/ou no trato digestivo podem ocasionar infecções.
Leitura complementar: Lista de batimentos cardíacos normais por idade
Este artigo é meramente informativo, no umCOMO não temos capacidade de receitar nenhum tratamento médico nem realizar nenhum tipo de diagnóstico. Convidamos você a recorrer a um médico no caso de apresentar qualquer tipo de condição ou mal-estar.
Se pretende ler mais artigos parecidos a Quais são os valores normais de neutrófilos, recomendamos que entre na nossa categoria de Doenças e Efeitos Secundários.